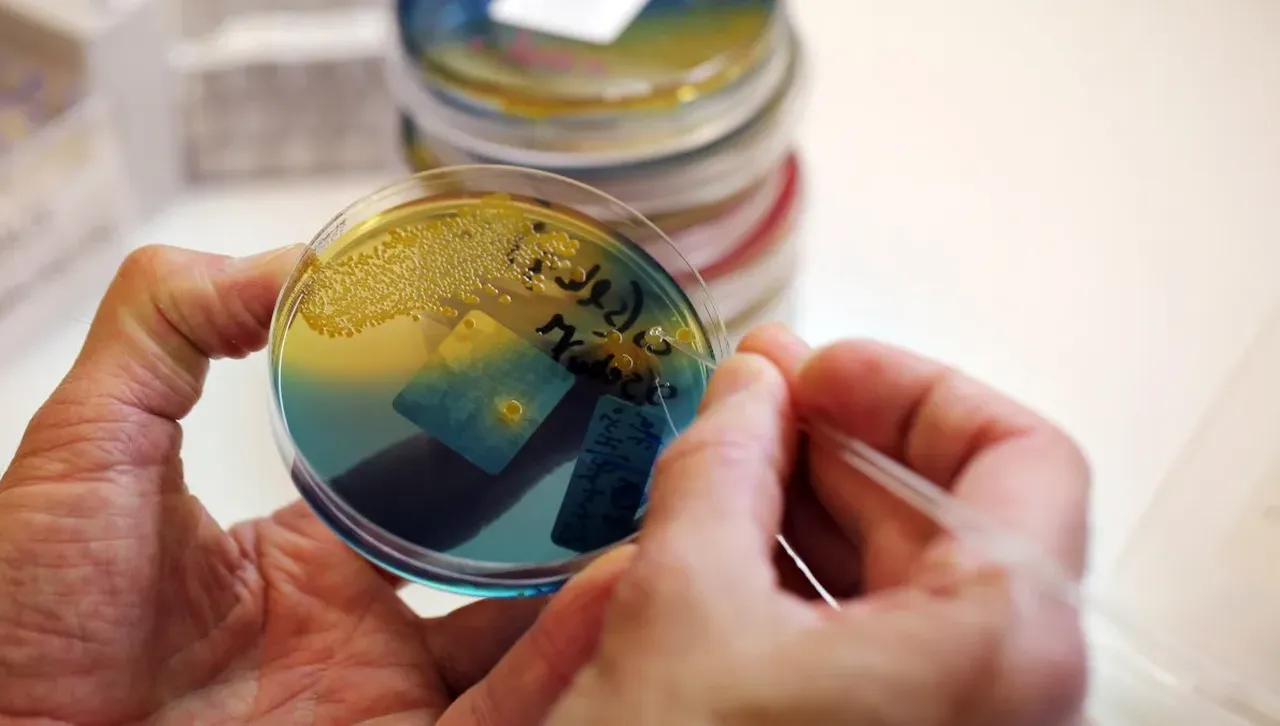
Създаването на огледални клетки? Учени са разтревожени дали не е опасен този експеримент

Изследователката Кейт Адамала не си спомня точно кога е осъзнала, че лабораторията ѝ в Университета на Минесота работи върху нещо потенциално опасно – толкова опасно, че някои изследователи смятат, че това може да представлява екзистенциален риск за всички форми на живот на Земята
Учени заключиха, че огледалните клетки биха могли да станат реалност през следващите 10 до 30 години и подробно описват потенциално опустошителните последици, ако огледални бактерии бъдат пуснати в околната среда и се разпространят, избягвайки естествения биологичен контрол и действайки като опасни патогени
Изследователката Кейт Адамала не си спомня точно кога е осъзнала, че лабораторията ѝ в Университета на Минесота работи върху нещо потенциално опасно – толкова опасно, че някои изследователи смятат, че това може да представлява екзистенциален риск за всички форми на живот на Земята.
Тя е една от четиримата изследователи, получили грант от 4 милиона долара от Националната научна фондация на САЩ през 2019 г., за да проучат дали е възможно да се създаде огледална клетка, в която структурата на всички нейни съставни биомолекули е обратна на тази, която се среща в нормалните клетки, съобщи CNN.
Работата е важна, смятат те, защото такива обърнати клетки, които никога не са съществували в природата, биха могли да хвърлят светлина върху произхода на живота и да улеснят създаването на молекули с терапевтична стойност, потенциално справяйки се със значителни медицински предизвикателства като инфекциозни заболявания и супербактерии. Но съмнението се прокрадва.
„Не беше момент на проблясване. Беше нещо като бавно кипене в продължение на няколко месеца“, каза Адамала, биолог, изследващ синтеза. Хората започнаха да задават въпроси, добави тя, „и ние си мислехме, че можем да им отговорим, а после осъзнахме, че не можем.“
Въпросите се въртяха около това какво би се случило, ако учените успеят да създадат „огледален организъм“ като бактерия, съставена от молекули, които са огледални образи на естествените им форми.
Може ли бактерията неволно да се разпространи неконтролирано в тялото или околната среда, представлявайки сериозни рискове за човешкото здраве и тежки последици за планетата? Или просто би се разпаднала и безобидно изчезнала безследно?
В природата структурата на много основни биомолекули е дясна или лява, въпреки че не е ясно защо животът е еволюирал по този начин. Това свойство, известно като хиралност, е открито за първи път от френския учен Луи Пастьор през 1848 г.
Например, ДНК и РНК са изградени от „десни“ нуклеотиди, а протеините са изградени от „леви“ аминокиселини. Точно както ръкавица за дясна ръка не може да пасне на лявата ръка, или както ключът пасва точно на ключалка, взаимодействията между молекулите често зависят от хиралността и живите системи се нуждаят от последователни модели на хиралност, за да функционират правилно.
В огледална клетка всички нейни молекули биха били заменени с огледално-образни версии. Подобно развитие е хипотетично; дори създаването на синтетична клетка с естествена хиралност, която имитира нормалните си живи аналози, все още не е възможно, но това е активна и вълнуваща област на изследване, която Адамала и няколко други изследователски групи търсят.
Учените могат да направят много от компонентите от неживи прекурсори и скоро биха могли да проектират нормални синтетични клетки, които на теория биха могли да създадат огледални едноклетъчни форми на живот, като бактерии.
Учените заключават, че огледалните клетки биха могли да станат реалност през следващите 10 до 30 години и подробно описва потенциално опустошителните последици, ако огледалните бактерии бъдат пуснати в околната среда и се разпространят, избягвайки естествения биологичен контрол и действайки като опасни патогени.
Оттогава организация с нестопанска цел, наречена Mirror Biology Dialogues Fund, спонсорира серия от срещи за разработване на препоръки, насочени към предотвратяване на заплахата, която учените смятат, че огледалният живот може да представлява.
Въпреки че има широко съгласие, че огледални организми като бактериите не трябва да се създават, има много дебати относно това какви - ако има такива - ограничения за изследване на огледалната биология трябва да съществуват.
Превод: Faktor.bg








Още от Наука
Астрономи откриха най-големите екзопланети, по-леки от памук
Те имат размерите на Юпитер, обикалят около звезда на повече от 1000 светлинни години разстояние и са открити от спътника TESS на НАСА
Учен: Времето не е вечно и един ден може да загуби смисъл
Може ли времето да изчезне? Ново изследване в областта на квантовата гравитация предполага, че времето не е фундаментална характеристика на Вселената. Според теорията то зависи от кривината на пространството и може постепенно да загуби значението си с разширяването на Космоса
INSAIT получи най-високото отличие на Европейския съвет за научни изследвания
За първи път българска научна институция е удостоена с такова отличие: "Постигнахме немислимото"